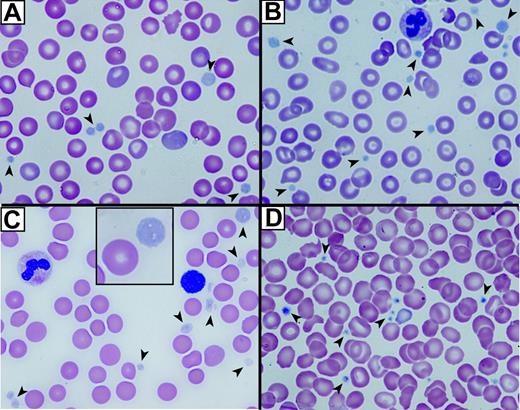
Figure 1. Abnormal platelets observed in blood films from patients with ARC syndrome. Romanowsky (Wright-Giemsa)–stained blood films from 3 patients with ARC syndrome (A-C) and a neonatal control (D) visualized using oil-immersion 63×/1.32-0.6 objective lenses). Large homogeneous, nongranular gray-appearing platelets (arrows) are observed in the fetal (A), the related neonatal (B), and unrelated neonatal (C) patients with ARC syndrome (A). Inset (C) shows magnified view of a typical large platelet compared with an erythrocyte taken from the top right corner of the underlying image. Normal neonatal control platelets (D) are typically smaller, granular, and stained dark blue (arrows).

Bleeding problems are associated with defects in platelet α-granules, yet little is known about how these granules are formed and released. Mutations affecting VPS33B, a novel Sec1/Munc18 protein, have recently been linked to arthrogryposis, renal dysfunction, and cholestasis (ARC) syndrome. We have characterized platelets from patients with ARC syndrome and observed reduced aggregation with arachidonate and adenosine diphosphate (ADP). Structural abnormalities seen in ARC platelets included increased platelet size, a pale appearance in blood films, elevated numbers of δ-granules, and completely absent α-granules. Soluble and membrane-bound α-granule proteins were significantly decreased or undetectable in ARC platelets, suggesting that both the releasable protein pools and membrane components of α-granules were absent. The role of VPS33B in platelet granule biogenesis was evaluated by immunofluorescence microscopy in normal human megakaryocytes. VPS33B colocalized appreciably with markers of α-granules, moderately with late endosomes/lysosomes, minimally with δ-granules/lysosomes, and not with cis-Golgi complexes. VPS33B protein expression determined by immunoblotting confirmed the presence of VPS33B in control fibroblasts but not in ARC fibroblasts, and in normal megakaryocytes but not in platelets. We conclude that like other Sec1/Munc18 proteins, VPS33B is involved in intracellular vesicle trafficking, being essential for the development of platelet α-granules but not for granule secretion.
Introduction
Congenital platelet disorders involving abnormalities in α and/or dense (δ) granules are an important cause of inherited bleeding disorders. A number of genes have been linked to the δ-granule defects associated with the Hermansky-Pudlak and Chediak-Higashi syndromes,1-6 and 16 genes have been identified in mice that regulate vesicle trafficking to platelet δ-granules and melanosomes; some of these genes encode known vesicle trafficking proteins whereas others encode components of BLOC (biogenesis of lysosome-related organelles complexes) protein complexes.3,7 Much less is known about the genes or proteins involved in α-granule defects, although some transcription factors and cell-surface glycoproteins have been implicated. For example, a family with X-linked macrothrombocytopenia and reduced α-granules was found to have an aspartate-to-glycine mutation in the transcription factor GATA1,8 and hemizygous loss of the FLI1 transcription factor causes the Paris-Trousseau syndrome, characterized by abnormal megakaryocytes and giant α-granules.9,10 In mice, loss of transcription factor NF-E2 expression produces abnormal megakaryocytes with absent α-granules,11 and hematopoietic zinc finger (Hzf)–deficient mice have megakaryocytes and platelets with reduced α-granules and α-granule proteins.12 Glycoprotein (GP) Ibβ–deficient mouse platelets contain abnormally large α-granules,13 and giant α-granules have also been observed in platelets from a patient with Bernard-Soulier syndrome.14 A deficiency of both platelet α- and δ-granules due to a defect in the cytosolic enzyme geranylgeranyl transferase, which attaches hydrophobic prenyl groups to Rab GTPases (guanosine 5′-triphosphatases), is seen in the gunmetal mouse.15,16 Rab27b localizes to α- and δ-granules in mouse megakaryocytes, where a dominant-negative Rab27 also interferes with proplatelet formation but not with α-granule protein transport.17 Ectopic expression of urokinase results in α-granule protein degradation and abnormal urokinase secretion in the Quebec platelet disorder,18 and deficiency or absence of α-granules and α-granule secretory proteins resulting in agranular gray-appearing platelets in Romanowsky stains is a feature of the Gray platelet syndrome (GPS), where the molecular defect is unknown.19-23
Arthrogryposis multiplex congenita, renal dysfunction, and cholestasis (ARC) syndrome was first described in 1973,24 and more than 30 families have since been reported.25-28 This autosomal recessive condition is associated with failure to thrive and death within the first year of life,25-27 and its other clinical manifestations include cerebral malformations, sensorineural deafness, congenital heart disease, nephrogenic diabetes insipidus, ichthyosis, dysmorphic features, recurrent febrile illnesses, diarrhea, and a bleeding diathesis. Bleeding problems observed in patients with ARC syndrome have included bleeding after renal or liver biopsy,26,27,29 cerebral hemorrhage,30 and gastrointestinal bleeding after treatment with indomethacin.31 While coagulation studies and platelet counts are usually normal, large platelets26 and a deficiency of α-granules31 have been observed. Mutation of VPS33B, a member of the Sec1/Munc18 (SM) protein family, has recently been shown to cause ARC syndrome.28
In this report, we describe the characterization of platelets from patients with ARC syndrome containing mutations in VPS33B. Platelet studies revealed the absence of platelet α-granules, increased δ-granules, and reduced platelet aggregation response to adenosine diphosphate (ADP) and arachidonate. Platelets from patients with ARC syndrome were found to be deficient in multiple α-granule proteins. Colocalization studies in normal human megakaryocytes indicated that VPS33B is associated with α-granules and/or α-granule precursors. Finally, we have demonstrated that VPS33B is normally present in megakaryocytes and not platelets, which implicates VPS33B in α-granule biogenesis but not in granule secretion.
Patients, materials, and methods
Patients
This study was performed according to the guidelines of the Research Ethics Board at The Hospital for Sick Children. Informed consent was provided according to the Declaration of Helsinki. A full-term female patient was born to healthy nonconsanguineous parents. Her neonatal clinical presentation has previously been described.27 The findings of arthrogryposis, conjugated hyperbilirubinemia, and renal tubular acidosis led to a diagnosis of ARC syndrome. The patient died at 2 months of age. Chorionic villi sampling was performed in a subsequent pregnancy in order to provide DNA for molecular prenatal diagnosis. The result was consistent with the fetus being affected, and the parents terminated the pregnancy. At pregnancy termination, fetal blood was sampled from the umbilical cord for platelet studies and for megakaryocyte culture to corroborate the result of the molecular analysis. Molecular studies confirmed that both the neonate and fetus carried compound heterozygous mutations in VPS33B, IVS12-2A > G and 1518C > T (R507X).28 Two unrelated patients with ARC syndrome containing the homozygous 1311C > T (R438X) VPS33B mutation28 were used for some studies, including platelet flow cytometry, platelet aggregation, fibroblast and platelet immunoblots, and microscopy (as indicated in the figure legends).
Platelet flow cytometry and aggregation
Platelet flow cytometry was performed according to published methods32 using fluorescein isothiocyanate (FITC)–conjugated CD41, CD42, and CD61 antibodies (Immunotech; Beckman Coulter, Buckinghamshire, United Kingdom) and an EPICS XL-MCL (Beckman Coulter) flow cytometer. Platelet aggregation studies were done with platelet-rich plasma (PRP; 230 × 109 platelets/L) using a PAP-4D (Bio Data, Horsham, PA) platelet aggregometer according to described methods.33
Bright field and electron microscopy
Romanowsky (Wright-Giemsa)–stained blood films were visualized and captured on a Leica DM LB2 microscope (Leica Microsystems, Richmond Hill, ON, Canada) equipped with a Leica DC 500 digital camera using a ×63/1.32-0.6 (magnification/numeric aperture [NA]) objective with oil immersion. Platelet whole-mount electron microscopy was done by placing 2 to 3 drops of PRP onto Formvar-coated nickel grids (Electron Microscopy Sciences, Fort Washington, PA) for 5 minutes whereby excess liquid was removed with a filter paper, followed by a 5-minute fixation with 2.5% glutaraldehyde in phosphate-buffered saline (PBS) pH 7.4. After rinsing with distilled water (dH2O) the grids were placed into a JEOL JEM-1230 electron microscope (EM; with a 300/20 μm condenser/objective aperture; Mississauga, ON, Canada) and the number of dense granules counted in a minimum of 50 platelets (×15 000-×100 000 magnification), to obtain the mean number of dense granules per platelet. For ultrastructural examination of platelets, PRP was centrifuged at 800g for 10 minutes and fixed with 2.5% glutaraldehyde in PBS pH 7.4 at 4°C for 1 hour. The supernatant was discarded and platelets were washed with 0.1 M phosphate buffer (pH 7.4), followed by dH2O. Platelets were then postfixed with 2% osmium tetroxide, dehydrated, and embedded in Epon. Thin sections were examined with a JEOL JEM-1230 electron microscope after uranyl acetate and lead citrate staining. Digital images were captured with a side-mounted Advantage HR CCD camera (Advanced Microsystems Techniques [AMT], Danvers, MA). Platelet morphometric analyses were done using ImageJ (version 1.33u) software as previously described.34 All digital images were imported into Adobe Photoshop 8.0 in RGB format and assembled in Adobe Illustrator 10.0 for labeling using an Apple Power Mac G4 computer.
Immunoblot analysis
Platelets were isolated from citrated whole blood by differential centrifugation at 150g for 10 minutes. The PRP was removed and washed 3 times in PBS/acid citrate dextrose (ACD) pH 6.1 by centrifugation at 1000g for 10 minutes. After counting (Z1 Coulter Counter; Beckman Coulter Canada, Mississauga, ON, Canada), 1 × 109 platelets/mL (final) were resuspended in PBS pH 7.4 containing protease inhibitor cocktail (5 mM EDTA; Complete; Roche Diagnostics, Laval, QC, Canada) and lysed by the addition of Triton X-100 (0.5% final). Fibroblast and megakaryocyte cells were lysed in PBS pH 7.4 with Triton X-100 (1% final) containing protease inhibitor cocktail, and the protein concentrations were determined using the BCA protein assay kit (Pierce Biotechnology, Rockford, IL). Aliquots of cell and platelet lysates were frozen and stored at -70°C until analyzed. Cell-lysate proteins and prestained molecular weight standards (SeeBlue Plus2; Invitrogen, Burlington, ON, Canada, or PageRuler; Fermentas Life Sciences, Burlington, ON, Canada) were resolved by sodium dodecyl sulfate–polyacrylamide gel electrophoresis (SDS-PAGE). Proteins were transferred onto nitrocellulose membranes in transfer buffer (25 mM Tris-HCl, pH 8.3, 192 mM glycine, 20% methanol) using a Bio-Rad (Mississauga, ON, Canada) mini Trans-Blot electrophoretic transfer cell. The membranes were blocked with 5% skim milk in TBS-T (20 mM Tris-HCl, 137 mM NaCl2, pH 7.6, 0.1% Tween 20) for 1 hour at room temperature (RT) or overnight at 4°C, and subsequently incubated with primary antibodies. The primary antibodies and the dilutions used for immunoblots included polyclonal goat anti–human fibrinogen (IgG fraction, 1:500; Rockland Immunochemicals, Gilbertsville, PA), polyclonal rabbit anti–human von Willebrand factor (VWF, 1:2000; DakoCytomation, Mississauga, ON, Canada), polyclonal rabbit anti–human P-selectin (1:500; BD Biosciences Pharmingen, Mississauga, ON, Canada), polyclonal rabbit anti–human platelet factor 4 (PF4, 1:2000; Chemicon International, Temecula, CA), mouse monoclonal anti–human thrombospondin-1 (TSP-1, clone D4.6, 1:200; Lab Vision, Fremont, CA), and mouse monoclonal anti–human β-actin (clone AC-15, 1:10 000; Sigma-Aldrich Canada, Oakville, ON, Canada). β-Thromboglobulin (β-TG) was detected using polyclonal rabbit anti–human NAP-2/CXCL7 (1:2500; PeproTech, Rocky Hill, NJ). Polyclonal anti–human VPS33B antibodies (1:100 for immunoblots) were generated by immunizing rabbits with a 16 amino acid peptide corresponding to the N-terminus of VPS33B coupled to KLH (keyhole limpet hemocyanin) through cysteine. Antibodies were subsequently affinity purified using peptide covalently linked to a SulfoLink column (Pierce Biotechnology) per manufacturer's instructions. After 3 washes, membranes were incubated with secondary horseradish peroxidase (HRP)–conjugated donkey antimouse, antirabbit, or antigoat antibodies (1:5000; Jackson ImmunoResearch Laboratories, West Grove, PA). Signals were developed with ECL chemiluminescent reagent (Amersham Biosciences, Baie d'Urfé, QC, Canada) and autoradiography film (Kodak X-Omat Blue XB-1). Some immunoblots were stripped with stripping buffer (62.5 mM Tris-HCl, 100 mM 2-mercaptoethanol, 2% SDS, pH 6.7) for 30 minutes followed by two 10-minute TBS-T washes and reprobed with different primary antibodies. Developed x-ray films were scanned with an Epson Perfection 3200 Photo scanner using the positive film mode.
Megakaryocyte culture
Cord blood (2 mL-3 mL) or peripheral blood from healthy adult volunteers (200 mL) was collected into tubes containing 3.8% sodium citrate. Cells were separated over a Ficoll-Paque PLUS (Amersham Biosciences) density gradient to obtain an enriched fraction of mononuclear cells. CD34+ cells were then isolated using immunomagnetic beads (Direct CD34 Progenitor Cell Isolation Kit, MiniMACS; Miltenyi Biotec, Auburn, CA) according to the manufacturer's recommendations. Megakaryocytes were cultured from the CD34+ cells in a serum-free culture system using Iscove modified Dulbecco medium (GIBCO; Invitrogen, Burlington, ON, Canada) containing 1% penicillin/streptomycin/glutamine and 15% BIT 9500 (StemCell Technologies, Vancouver, BC, Canada) supplemented with 50 ng/mL or 100 ng/mL recombinant pegylated human megakaryocyte growth and development factor (rhPEG-MGDF; gift from Kirin Brewery Company, Tokyo, Japan) with or without 50 ng/mL recombinant-methionyl human stem-cell factor (Stemgen; Amgen Canada, Mississauga, ON, Canada) for 11 to 12 days. We routinely obtained more than 80% megakaryocytes as assessed by CD41 labeling.
Immunofluorescence microscopy
Human megakaryocyte cells (cultured for 12 days) were mixed with human albumin (25% final concentration) and gently cytocentrifuged onto glass slides (Shandon Cytospin 4 Cytocentrifuge; Thermo Electron, Waltham, MA). Cells were fixed with 4% paraformaldehyde for 30 minutes followed by treatment with PBS containing 25 mM glycine and 25 mM NH4Cl pH 7.4, for 15 minutes at RT. Fixed cells were rinsed with PBS and permeabilized with 0.1% (vol/vol) Triton X-100 for 5 minutes followed by washes with PBS. Permeabilized cells were blocked with blocking solution (PBS, 1% bovine serum albumin, 2% goat serum) for 1 hour at RT. Cells were labeled with primary antibodies (diluted in blocking solution) for 1 hour followed by three 15-minute washes with PBS. Labeling with secondary antibodies was identical. The primary antibodies used for immunofluorescence microscopy included polyclonal rabbit anti–human VPS33B, monoclonal mouse anti–human VWF (clone F8/86; DakoCytomation, Mississauga, ON, Canada), monoclonal mouse anti–human CD63 (clone H5C6; BD Transduction Laboratories, BD Biosciences, Mississauga, ON, Canada), monoclonal mouse anti–human LAMP-1 (clone H4A3; Developmental Studies Hybridoma Bank, University of Iowa, Iowa City, IA), and monoclonal mouse anti–human GM130 (clone 35; BD Transduction Laboratories, BD Biosciences). Secondary antibodies used at 1:500 dilution included Alexa Fluor 488 goat antirabbit (Molecular Probes; Invitrogen, Burlington, ON, Canada) and Cy3 donkey antimouse (Jackson ImmunoResearch Laboratories). Slides were mounted using DAKO Fluorescence Mounting Medium (DakoCytomation, Mississauga, ON, Canada). Fluorescence images were captured with a Zeiss LSM 510 META laser scanning microscope using a 63×/1.4 oil-immersion objective. Representative Z-stack digital images were acquired with Zeiss LSM 510 META software (version 3.2) and made into the final figures as described in “Bright field and electron microscopy.”
Results
Bleeding in the ARC neonate
Evaluation of bleeding in the ARC neonate included a complete blood count at birth, which revealed a hemoglobin level of 228 g/L, white blood cell count of 17.85 × 109/L, and platelet count of 309 × 109/L. The mean platelet volume was 12.1 fL. Coagulation parameters including fibrinogen, international normalized ratio (INR), and partial thromboplastin time (PTT) were normal, as were factors V, VII, VIII, and IX. Nonetheless, severe hemorrhage secondary to a liver biopsy occurred despite RBC, fluid, and fresh frozen plasma replacement, requiring packing and suturing for establishment of hemostasis. Abnormal function of ARC platelets was suggested by the bleeding phenotype in the face of a normal platelet count and normal coagulation parameters. Qualitative platelet function abnormalities in patients with ARC syndrome were demonstrated by platelet aggregation studies (not shown), in which reduced aggregation was seen with arachidonate, and an absent secondary aggregation wave with ADP. Flow cytometry of ARC platelets (not shown) confirmed normal levels of CD41, CD42, and CD61, indicating normal levels of glycoproteins GPIIb/IIIa (integrin αIIbβ3) and GPIb.
Structural abnormalities of ARC platelets
The first indication that ARC platelets were structurally abnormal was their large, pale, and agranular appearance in stained blood films (Figure 1A-C) compared with control neonatal platelets (Figure 1D). Both fetal (Figure 1A) and neonatal ARC platelets from 2 different neonates (Figure 1B-C) had agranular platelets that were often very large (Figure 1C, inset). The staining pattern was reminiscent of that seen in Gray platelets, which are known to contain markedly reduced α-granules22,35 but normal δ-granules and lysosomes.36
In order to assess the α-granule content and analyze the ultrastructure of ARC platelets, thin section EM was performed as shown in Figure 2. ARC platelet α-granule deficiency was clearly evident in electron micrographs (Figure 2A-B) when compared with control fetal platelets showing numerous α-granules (Figure 2C). Prominent Golgi complexes were also visible in ARC platelets (Figure 2B, near the center of the platelet). The α-granule deficiency in ARC platelets was confirmed by quantitative ultrastructural morphometric34 comparisons of neonatal and fetal ARC platelets with healthy controls (ARC patient platelets, n = 100; control platelets, n = 25), which revealed absent α-granules in both neonate and fetus, compared with an average of 5.5 α-granules per platelet section in controls. The ARC neonatal platelet diameter was 3.2 μm (average) compared with the reported normal value of 2.2 μm.34 Dense granule quantification of ARC neonatal platelets (n = 2 patients with ARC, 112 platelets counted) using whole-mount EM revealed numerous small densities (> 25 in 23/112 platelets, 1-19 in 32/112 platelets), in addition to no densities in 57 of 112 platelets. For comparison, no normal neonatal platelets (n = 4 neonates, 271 platelets counted) were observed to have more than 25 densities, although small densities (1-12) were seen in 162 of 271 platelets and no densities were seen in 109 of 271 platelets. The average dense granule count per platelet in ARC and neonatal controls was 6.5 and 1.4 per platelet, respectively (where > 25 was counted as 25), suggesting the presence of increased δ-granules in ARC platelets. Elevated numbers of platelet δ-granules were also evident in EM thin sections of ARC platelets, where multiple dense granules could often be seen, as shown in Figure 2D. Thus, ultrastructural studies of ARC platelets confirmed the undetectability of α-granules, and provided indications of increased numbers of δ-granules in patients with mutations in VPS33B.
Abnormal platelets observed in blood films from patients with ARC syndrome. Romanowsky (Wright-Giemsa)–stained blood films from 3 patients with ARC syndrome (A-C) and a neonatal control (D) visualized using oil-immersion 63×/1.32-0.6 objective lenses). Large homogeneous, nongranular gray-appearing platelets (arrows) are observed in the fetal (A), the related neonatal (B), and unrelated neonatal (C) patients with ARC syndrome (A). Inset (C) shows magnified view of a typical large platelet compared with an erythrocyte taken from the top right corner of the underlying image. Normal neonatal control platelets (D) are typically smaller, granular, and stained dark blue (arrows).
Abnormal platelets observed in blood films from patients with ARC syndrome. Romanowsky (Wright-Giemsa)–stained blood films from 3 patients with ARC syndrome (A-C) and a neonatal control (D) visualized using oil-immersion 63×/1.32-0.6 objective lenses). Large homogeneous, nongranular gray-appearing platelets (arrows) are observed in the fetal (A), the related neonatal (B), and unrelated neonatal (C) patients with ARC syndrome (A). Inset (C) shows magnified view of a typical large platelet compared with an erythrocyte taken from the top right corner of the underlying image. Normal neonatal control platelets (D) are typically smaller, granular, and stained dark blue (arrows).
Absent α-granules and increased δ-granules in platelets from patients containing mutations in VPS33B. Thin-section transmission electron micrographs of representative platelets from related ARC fetal (A) and neonatal (B) blood, control fetal (C), and unrelated ARC neonatal (D) blood. Magnifications are ×30 000 (A-C) and ×25 000 (D). The black bar represents 500 nm. Multiple α-granules (white arrows) are seen in the control platelet (C), and are absent in ARC platelets (A, B, D). The dark-staining structures seen in ARC platelets (A, B, D) contain distinct internal membranes and may represent mitochondria. Prominent Golgi structures are also visible in ARC platelets (eg, near the center of the platelet in panel B). Multiple dark densities encircled by a lighter halo representing δ-granules (arrows) are visualized in a single thin-section EM image of a neonatal ARC platelet (D), where one would expect to see less than the average of 0.4 δ-granules per platelet thin section observed in adults.34
Absent α-granules and increased δ-granules in platelets from patients containing mutations in VPS33B. Thin-section transmission electron micrographs of representative platelets from related ARC fetal (A) and neonatal (B) blood, control fetal (C), and unrelated ARC neonatal (D) blood. Magnifications are ×30 000 (A-C) and ×25 000 (D). The black bar represents 500 nm. Multiple α-granules (white arrows) are seen in the control platelet (C), and are absent in ARC platelets (A, B, D). The dark-staining structures seen in ARC platelets (A, B, D) contain distinct internal membranes and may represent mitochondria. Prominent Golgi structures are also visible in ARC platelets (eg, near the center of the platelet in panel B). Multiple dark densities encircled by a lighter halo representing δ-granules (arrows) are visualized in a single thin-section EM image of a neonatal ARC platelet (D), where one would expect to see less than the average of 0.4 δ-granules per platelet thin section observed in adults.34
α-granule proteins are deficient in ARC megakaryocytes and platelets
In order to demonstrate that the observed ultrastructural α-granule deficiency in ARC platelets was also accompanied by a deficit of α-granule proteins in ARC megakaryocytes and platelets, we analyzed a number of proteins using immunoblots (Figures 3 and 4). Equivalent sample loading was achieved by loading lysates from similar numbers of cells or platelets, and confirmed by measuring total protein concentrations and probing for actin. α-granule protein deficiency in ARC megakaryocytes was indicated by the decreased amount of PF4 observed by immunoblotting (Figure 3A). Limited availability of ARC megakaryocyte material did not permit a similar analysis of other α-granule proteins. We were, however, able to evaluate platelet α-granule proteins from an unrelated patient with ARC syndrome, and these studies confirmed the observation of markedly reduced amounts of PF4 in ARC platelets when compared with normal neonatal and adult platelets (Figure 3B). We also demonstrated that VWF was not detectable in ARC platelets (Figure 3C), whereas it was present in normal amounts in the patient's plasma (Figure 3D), suggesting that VWF synthesis was unaffected. Similarly, minimal β-TG was noted in ARC platelets compared with normal neonatal and adult platelets (Figure 4A). Both TSP-1 (Figure 4B) and fibrinogen (Figure 4C) were undetectable in ARC platelets compared with platelets from a healthy neonatal control. Fibrinogen, however, was present in normal amounts in plasma from patients with ARC syndrome (not shown), confirming normal protein synthesis. Taken together, these observations demonstrate a marked deficiency of both endogenously synthesized (PF4, VWF, β-TG, TSP-1) and plasma-derived (fibrinogen)37 soluble α-granule proteins in ARC platelets.
It has been reported that platelet α-granule membranes are intact in patients with GPS, a conclusion based on immunolocalization of the α-granule membrane protein P-selectin in resting and activated platelets, and its presence in platelet lysates.22,38 To determine whether the α-granule membrane protein P-selectin was present in ARC platelets, we probed for P-selectin in ARC platelet lysates using immunoblotting (Figure 4D). As shown in Figure 4D, virtually no P-selectin was detectable in ARC platelets compared with those of 2 neonatal and 1 adult control. These results suggest that unlike those associated with the GPS, ARC platelets lack α-granule membrane structures.
α-granule protein deficiencies in ARC megakaryocytes and platelets. Immunoblots comparing megakaryocyte (MK) and platelet (PLT) whole-cell lysates or plasma from ARC and normal (N) fetal, neonatal, and adult sources as indicated for each lane. (A) Markedly reduced PF4 content in ARC fetal megakaryocytes (lane 1) compared with control fetal megakaryocytes (lanes 2, 3), control adult platelets (lane 4), and megakaryocytes (lane 5) were observed (reduced 10% SDS-PAGE). Lysate from equivalent numbers of megakaryocytes (CD41+-labeled cells) was loaded for lanes 1 to 3. Equivalent protein loading is indicated by visualizing actin on the same blot. (B) Significantly decreased PF4 was also observed in ARC neonatal platelets (lane 1) compared with normal neonatal (lanes 2, 3) and adult (lane 4) platelets (reduced 15% SDS-PAGE; PF4 and actin were probed and developed simultaneously). (C) Platelet VWF is undetectable in ARC platelets (lane 1) compared with normal neonatal (lanes 2, 3) and adult (lane 4) platelets (reduced 8% SDS-PAGE). (D) In contrast, VWF was present at roughly equivalent quantities (0.5 μL plasma/lane) in plasma from patients with ARC syndrome (lane 1) compared with normal neonatal (lanes 2, 3) and adult (lane 4) control plasma (reduced 8% SDS-PAGE).
α-granule protein deficiencies in ARC megakaryocytes and platelets. Immunoblots comparing megakaryocyte (MK) and platelet (PLT) whole-cell lysates or plasma from ARC and normal (N) fetal, neonatal, and adult sources as indicated for each lane. (A) Markedly reduced PF4 content in ARC fetal megakaryocytes (lane 1) compared with control fetal megakaryocytes (lanes 2, 3), control adult platelets (lane 4), and megakaryocytes (lane 5) were observed (reduced 10% SDS-PAGE). Lysate from equivalent numbers of megakaryocytes (CD41+-labeled cells) was loaded for lanes 1 to 3. Equivalent protein loading is indicated by visualizing actin on the same blot. (B) Significantly decreased PF4 was also observed in ARC neonatal platelets (lane 1) compared with normal neonatal (lanes 2, 3) and adult (lane 4) platelets (reduced 15% SDS-PAGE; PF4 and actin were probed and developed simultaneously). (C) Platelet VWF is undetectable in ARC platelets (lane 1) compared with normal neonatal (lanes 2, 3) and adult (lane 4) platelets (reduced 8% SDS-PAGE). (D) In contrast, VWF was present at roughly equivalent quantities (0.5 μL plasma/lane) in plasma from patients with ARC syndrome (lane 1) compared with normal neonatal (lanes 2, 3) and adult (lane 4) control plasma (reduced 8% SDS-PAGE).
Soluble and membrane-bound α-granule protein deficiencies in ARC platelets and the presence of VPS33B in normal fibroblasts and megakaryocytes. Immunoblots comparing megakaryocyte (MK) and platelet (PLT) or fibroblast whole-cell lysates from ARC and normal (N) neonatal and adult sources as indicated for each lane. Actin was visualized as a protein concentration loading control. (A) Significantly decreased β-TG was observed in ARC neonatal platelets (lane 1) compared with normal neonatal (lanes 2, 3) and adult (lane 4) platelets (reduced 15% SDS-PAGE; β-TG and actin were probed and developed simultaneously). (B) ARC platelets contained undetectable amounts of TSP-1 (lane 1) compared with normal neonatal platelets (lane 2, reduced 10% SDS-PAGE). (C) Fibrinogen was undetectable in ARC platelets (lane 1) despite its normal presence in neonatal control platelets (lane 2, nonreduced 9% SDS-PAGE) and ARC plasma (not shown). (D) The α-granule membrane-containing protein P-selectin was virtually undetectable in ARC platelets (lane 1) when compared with normal neonatal (lanes 2, 3) and adult (lane 4) platelets (reduced 8% SDS-PAGE, stripped VWF blot from Figure 3C). (E) Affinity-purified polyclonal anti–human VPS33B detected VPS33B in normal neonatal fibroblasts (lane 2) and normal adult megakaryocytes (lane 3), but not in ARC neonatal fibroblasts (lane 1) or normal adult control platelets (lane 4). Actin immunostaining is shown on the same blot.
Soluble and membrane-bound α-granule protein deficiencies in ARC platelets and the presence of VPS33B in normal fibroblasts and megakaryocytes. Immunoblots comparing megakaryocyte (MK) and platelet (PLT) or fibroblast whole-cell lysates from ARC and normal (N) neonatal and adult sources as indicated for each lane. Actin was visualized as a protein concentration loading control. (A) Significantly decreased β-TG was observed in ARC neonatal platelets (lane 1) compared with normal neonatal (lanes 2, 3) and adult (lane 4) platelets (reduced 15% SDS-PAGE; β-TG and actin were probed and developed simultaneously). (B) ARC platelets contained undetectable amounts of TSP-1 (lane 1) compared with normal neonatal platelets (lane 2, reduced 10% SDS-PAGE). (C) Fibrinogen was undetectable in ARC platelets (lane 1) despite its normal presence in neonatal control platelets (lane 2, nonreduced 9% SDS-PAGE) and ARC plasma (not shown). (D) The α-granule membrane-containing protein P-selectin was virtually undetectable in ARC platelets (lane 1) when compared with normal neonatal (lanes 2, 3) and adult (lane 4) platelets (reduced 8% SDS-PAGE, stripped VWF blot from Figure 3C). (E) Affinity-purified polyclonal anti–human VPS33B detected VPS33B in normal neonatal fibroblasts (lane 2) and normal adult megakaryocytes (lane 3), but not in ARC neonatal fibroblasts (lane 1) or normal adult control platelets (lane 4). Actin immunostaining is shown on the same blot.
VPS33B is absent in ARC fibroblasts and normal platelets
Since the genetic defect in our patients with ARC syndrome has been shown to be due to mutations in VPS33B,28 we wanted to investigate VPS33B protein expression in ARC cells as well as in normal megakaryoctes and platelets. It has been shown that the VPS33B gene is widely expressed in mammalian cells.39 VPS33B protein expression tested by immunoblotting confirmed the presence of VPS33B in control fibroblasts, but not in ARC fibroblasts (Figure 4E). VPS33B protein was also observed in normal megakaryocytes but not in platelets. Taken together, these results demonstrate that VPS33B is absent in ARC cells and that this protein is involved in normal megakaryocyte and platelet granule biogenesis, but not in platelet secretion.
Localization of VPS33B in normal megakaryocytes
While the total relative numbers of megakaryocytes detected via CD41+ flow cytometry were similar to controls, ARC megakaryocytes grown in culture were seen to contain numerous vacuole-like structures when compared with cultured control fetal megakaryocytes (not shown), indicating developmental abnormalities during megakaryocyte maturation. Limited amounts of patient material did not allow us to perform any ultrastructural studies of ARC megakaryocytes. Instead, we investigated the role of VPS33B during megakaryocyte granule biogenesis by performing colocalization studies with different vesicular markers in normal human megakaryocytes (Figure 5). These studies were done in triplicate and representative images were taken. The affinity-purified anti–human VPS33B antibody stains megakaryocytes in a granular pattern throughout the cytoplasm (Figure 5). VPS33B was found to colocalize appreciably but not completely with VWF (Figure 5A), a multivesicular body (MVB) and α-granule marker.22,40 LAMP-1 (lysosomal-associated membrane protein-1), which is a late endosome/lysosome membrane marker,41 partially colocalized with VPS33B (Figure 5B). Serotonin is a specific marker of δ-granules, but we were unable to obtain satisfactory immunofluorescence staining using different commercially available serotonin-specific antibodies. Minimal colocalization of VPS33B was observed with CD63 (LAMP-3; Figure 5C), a membrane protein normally found in MVBs, δ-granules, and lysosomes of megakaryocytes.40,42,43 VPS33B did not colocalize with the cis-Golgi complex marker GM13044 in normal megakaryocytes (Figure 5D). These results suggest that in normal megakaryocytes, VPS33B interacts appreciably with α-granules and/or α-granule precursors (MVBs), moderately with late endosomes (likely not with lysosomes because of minimal colocalization with CD63), and minimally with δ-granules and/or δ-granule precursors (MVBs).
Immunofluorescent localization of VPS33B with α-granule, late endosome/lysosome, δ-granule/lysosome, and Golgi complex markers in normal human megakaryocytes. Human cultured megakaryocytes were cytocentrifuged onto glass slides, fixed, permeabilized, and labeled with polyclonal rabbit anti-VPS33B antibodies together with monoclonal antibodies to VWF (A), LAMP-1 (B), CD63 (C), and GM130 (D), followed by labeling with secondary Alexa Fluor 488 goat antirabbit and Cy3 donkey antimouse antibodies. Stained megakaryocytes were visualized by confocal microscopy where multilobed nuclei (unique to megakaryocytes) could be recognized readily using the differential interference contrast mode. Staining was typically granular. Representative images are shown and the white bar corresponds to 10 μm. (A) The merged images revealed significant partial colocalization (yellow) of VPS33B with VWF. (B) Although partial colocalization of VPS33B with LAMP-1 was observed (merged), it was less than with VWF. (C) VPS33B colocalized minimally with CD63 (merged). (D) No colocalization of VPS33B with GM130 was detected (merged).
Immunofluorescent localization of VPS33B with α-granule, late endosome/lysosome, δ-granule/lysosome, and Golgi complex markers in normal human megakaryocytes. Human cultured megakaryocytes were cytocentrifuged onto glass slides, fixed, permeabilized, and labeled with polyclonal rabbit anti-VPS33B antibodies together with monoclonal antibodies to VWF (A), LAMP-1 (B), CD63 (C), and GM130 (D), followed by labeling with secondary Alexa Fluor 488 goat antirabbit and Cy3 donkey antimouse antibodies. Stained megakaryocytes were visualized by confocal microscopy where multilobed nuclei (unique to megakaryocytes) could be recognized readily using the differential interference contrast mode. Staining was typically granular. Representative images are shown and the white bar corresponds to 10 μm. (A) The merged images revealed significant partial colocalization (yellow) of VPS33B with VWF. (B) Although partial colocalization of VPS33B with LAMP-1 was observed (merged), it was less than with VWF. (C) VPS33B colocalized minimally with CD63 (merged). (D) No colocalization of VPS33B with GM130 was detected (merged).
Discussion
The development of platelet secretory granules is poorly understood. The available evidence indicates that α-granules develop from budding vesicles in the Golgi complex within megakaryocytes, from where they mature into MVBs, which can interact with endocytotic vesicles.40,45 MVBs, which are abundant in young megakaryocytes, are thought to be common precursors of both α- and δ-granules.40,43,45 Morphologically, at least 2 MVBs containing α-granule proteins (VWF, β-TG, P-selectin) and δ-granule/lysosomal proteins (CD63) can be distinguished: type I have internal vesicles only, and type II have internal vesicles and an electron-dense matrix.40,43 While MVBs provide common sorting compartments for α- and δ-granule maturation, the mechanism by which these granules develop into distinct entities is unknown. A number of proteins have been implicated in δ-granule biogenesis based on studies of mouse models and humans with the Hermansky-Pudlak syndrome.1-3 These include known vesicular trafficking proteins such as the alpha subunit of Rab geranylgeranyl transferase, VPS33A, Rab27a, the β3A and δ subunits of AP-3, as well as novel proteins that form BLOC complexes.3 Much less is known about the genes and proteins required for α-granule biogenesis.
We have characterized platelets from patients with ARC syndrome arising from known mutations in the vesicular trafficking protein VPS33B. The functional impairment of these platelets was indicated by bleeding complications described in our patient and in other ARC cases,26,29-31 and a qualitative platelet function defect was further demonstrated by the abnormal platelet aggregation observed with ADP and arachidonate. ARC platelets were not completely dysfunctional, since they contained normal levels of GPIIb/IIIa and GPIb on the plasma membrane and could be stimulated to aggregate normally with other agonists. ARC platelets were found to have increased δ-granules, undetectable α-granules, and markedly decreased to absent α-granule protein constituents. As expected, VPS33B expression was observed in normal but not ARC fibroblasts. VPS33B expression was also observed in normal megakaryocytes but not in platelets, suggesting a critical role for this protein in α-granule biogenesis but not in platelet secretion or other functions.
Normal platelets contain from 50 to 80 α-granules, each measuring between 200 nm to 500 nm and enclosed by a membrane.37 Four distinct regions can be distinguished within α-granules based on ultrastructural and immunolabeling studies.37,46-48 These regions include the peripheral membrane (containing P-selectin), tubular structures (containing multimeric VWF), an electron dense nucleoid (containing β-TG and PF4), and an electron lucent region (containing fibrinogen and TSP-1). Proteomic analysis of proteins released from activated human platelets has identified more than 300 proteins, many of which reside within α-granules.49 The basophilic protein content of platelet α-granules contributes to the dark blue staining pattern seen in normal platelet blood films, and the initial indication of α-granule deficiency in ARC platelets was their abnormally pale and agranular appearance in blood films, similar to what is observed in GPS platelets.22 Further evidence that ARC platelets contain no recognizable α-granules was provided by thin-section EM analysis. Quantitative ultrastructural morphometric34 comparisons of ARC platelets with normal control platelets confirmed absent α-granules in ARC platelets, relative to an average of 5.5 α-granules per platelet section seen in controls, which is comparable to published data.34,50 Whole-mount EM established the presence of increased δ-granules in ARC platelets compared with normal neonate platelets. This was further supported by thin-section EM micrographs where multiple δ-granules could often be seen (Figure 2D), compared with an expected frequency of 0.4 δ-granules per thin section34 (normal human adult platelets contain 3 to 8 δ-granules per platelet).4 In fact, we found that normal neonatal platelets contained an average of 1.4 δ-granules per platelet.
Taken together, our ultrastructural studies demonstrated undetectable α-granule structures in all ARC platelets examined, and increased δ-granules in numerous ARC platelets. These observations indicate that VPS33B-mediated α-granule formation in megakaryocytes is distinct from that of δ-granule formation. Why ARC platelets contain elevated numbers of δ-granules is not known. It is tempting to speculate, based on studies showing platelet granules being actively transported from mature megakaryocytes into forming proplatelets,51 that a deficiency of α-granules within megakaryocytes triggers the transport of additional δ-granules into proplatelets.
Normal platelets store megakaryocyte-synthesized and plasma-derived proteins within α-granules. EM immunolocalization studies have shown that VWF is synthesized by megakaryocytes and stored within α-granules.21,52 VWF is also expressed in endothelial cells, from where it is either constitutively secreted or stored as multimeric VWF in Weibel-Palade bodies.53 The observation of normal VWF levels in plasma from patients with ARC syndrome and undetectable levels within platelets suggests that the packaging defect of VWF is confined to ARC megakaryocytes. Abnormal VWF processing in megakaryocte α-granules but not in endothelial cells is also seen in the GPS.54,55 The plasma-derived α-granule protein fibrinogen, which is normally acquired by megakaryocytes and platelets through αIIbβ3-dependent endocytosis,56-58 was also not detected in ARC platelets despite its normal presence in plasma. A deficiency of both megakaryocyte-synthesized (β-TG, PF4, VWF, TSP-1)37 and endocytosed (fibrinogen) soluble α-granule proteins further suggests that ARC megakaryocytes are unable to capture and package proteins into α-granule compartments, analogous to what is seen in the GPS.36,59
An absence of α-granule membrane structures could explain the inability of ARC megakaryocytes and/or platelets to package proteins into α-granule compartments. This possibility is supported by the markedly reduced to absent α-granule membrane protein P-selectin found in ARC platelets (Figure 4D). This type I integral membrane protein normally resides within α-granules of unstimulated platelets and is translocated to the plasma membrane upon platelet activation.60 Although P-selectin has also been observed in δ-granules,61,62 it is likely less abundant there. Increased δ-granules and undetectable α-granules within ARC platelets were shown using EM (Figure 2). Taken together, the P-selectin deficit observed in ARC platelets per immunoblots is likely reflective of missing α-granule membranes. This is in contrast to what is observed in the GPS, where both EM immunolocalization studies and immunoblots have detected P-selectin,38 albeit at decreased levels in some patients.42,63 Intact α-granule membranes in the GPS are also indicated by the presence of other α-granule membrane proteins αIIbβ3, CD36, and GPIb-IX-V in platelets.22 Thus, the molecular mechanism culminating in α-granule deficiency in ARC platelets is likely distinct from that in GPS platelets.
All patients with ARC syndrome studied in this report contain known mutations in the VPS33B gene,28 and our studies confirmed the absence in ARC fibroblasts of detectable VPS33B protein, which was present in normal fibroblasts and megakaryocytes. VPS33B is a 70.6-kDa protein and a member of the SM protein family.28 SM proteins have a high affinity for membrane-associated soluble N-ethylmaleimide-sensitive fusion (NSF) attachment protein receptors (SNAREs) of the syntaxin subfamily.64 Vesicle SNAREs interact with target SNAREs to drive membranes into close proximity promoting vesicle fusion, which is a fundamental process in all cells.65,66 SM proteins are critical, since loss of a specific SM protein abolishes the respective fusion process and is often lethal in null-mutant mice.64 The precise regulatory role of SM proteins in mammalian vesicular fusion is not understood, and the picture is complicated by the heterogenous binding interactions observed with SNAREs.64,65,67 Munc18a-c are 3 SM proteins known to be present in platelets and involved in granule secretion.68-70 A mutation in a related SM protein, VPS33A (31% amino acid identity to VPS33B),71 has been shown to cause a bleeding phenotype and platelet δ-granule deficiency in buff mice.72 As with other SM proteins, VPS33B is predicted to be involved in vesicle trafficking and may be part of a multiprotein complex as seen in yeast (HOPS complex),73-77 which binds SNAREs and facilitates membrane docking and fusion necessary for α-granule formation.
To gain insights into the role that VPS33B plays in normal megakaryocyte vesicular trafficking, colocalization studies with markers of cellular compartments were performed. These studies demonstrated significant partial colocalization of VPS33B with α-granules and/or α-granule precursor MVBs (VWF). The incomplete colocalization can be explained if VPS33B is only required at a specific α-granule maturation stage, where it would be in close proximity, but not at an earlier or later stage. The modest partial colocalization observed with late endosomes/lysosomes (LAMP-1) suggests that this compartment also interacts with VPS33B. Minimal colocalization with δ-granules/lysosomes (CD63) suggests that these structures do not interact with VPS33B and makes it likely that the interaction with LAMP-1 is mostly confined to late endosomes. Prominent colocalization of LAMP-1 (none with GM130) with ectopically overexpressed GFP-VPS33B was seen in RCC4 cells (renal-cell carcinoma cell line),28 suggesting cell-specific and/or concentration-dependent effects. Our studies showed that VPS33B did not colocalize with the cis-Golgi complex (GM130), indicating that the cis-Golgi apparatus is not involved in α-granule biogenesis. A model can be proposed where VPS33B interacts specifically but temporarily with precursor/α-granule membrane compartments, thus allowing the formation of mature α-granules within megakaryocytes. Late endosomes may also interact with VPS33B; however, little interaction is predicted to occur with lysosome and δ-granule membranes. These results reveal the essential role of VPS33B in α-granule but not δ-granule biogenesis in human megakaryocytes and platelets. The detection of VPS33B in normal megakaryocytes but not platelets indicates that VPS33B is required for α-granule formation but not for secretion from platelets. Identification of VPS33B as an essential component of human platelet α-granule biogenesis with a likely role in vesicle trafficking and fusion represents an important new insight into a process that has until recently been poorly understood.
Prepublished online as Blood First Edition Paper, August 25, 2005; DOI 10.1182/blood-2005-04-1356.
B.L. and L.L. contributed equally to this work.
An Inside Blood analysis of this article appears in the front of this issue.
The publication costs of this article were defrayed in part by page charge payment. Therefore, and solely to indicate this fact, this article is hereby marked “advertisement” in accordance with 18 U.S.C. section 1734.
We thank Drs F. Pluthero, M. Rand, and W. Trimble for critical review of the manuscript, and J. Brumell for technical assistance with the immunofluorescence microscopy. We also thank the Kirin Brewery Company for their generous gift of recombinant pegylated human megakaryocyte growth and development factor.

This feature is available to Subscribers Only
Sign In or Create an Account Close Modal